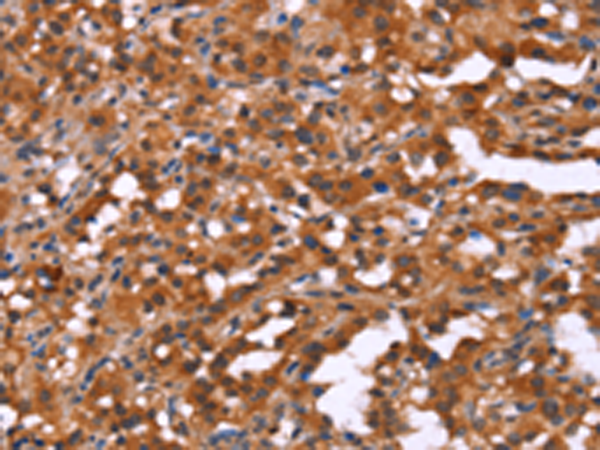
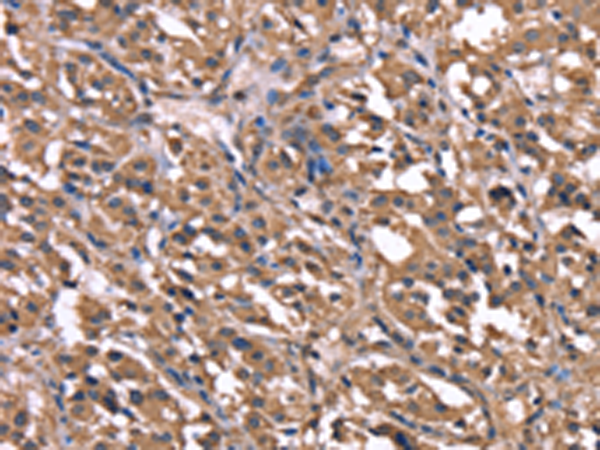

-
分类: 科研抗体货号: P11812别名: HINT; NMAN; PKCI-1; PRKCNH1应用: WB,IHC反应种属: Human, Mouse, Rat
-
分类: 科研抗体货号: P11823别名: HPRG; HRGP; THPH11应用: IHC反应种属: Human
-
分类: 科研抗体货号: P11805别名:应用: IHC反应种属: Human, Mouse
-
分类: 科研抗体货号: P11811别名: MDS027; hHBrk1; C3orf10; HSPC300应用: IHC反应种属: Human, Mouse
-
分类: 科研抗体货号: P11822别名: HOX2; HOX2F; HOX-2.6应用: WB反应种属: Human, Mouse
-
分类: 科研抗体货号: P11804别名: TDAG8; hTDAG8应用: IHC反应种属: Human
-
分类: 科研抗体货号: P11810别名: HHL; HRY; HES-1; bHLHb39应用: IHC反应种属: Human, Mouse, Rat
-
分类: 科研抗体货号: P11821别名: HNRPH; HNRPH1; hnRNPH应用: WB反应种属: Human, Mouse, Rat
-
分类: 科研抗体货号: P11838别名: IDB4; bHLHb27应用: IHC反应种属: Human, Mouse
-
分类: 科研抗体货号: P11820别名: HNRPF; mcs94-1; OK/SW-cl.23应用: WB反应种属: Human, Mouse, Rat

鄂公网安备42018502007531号
鄂公网安备42018502007531号

